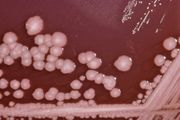

مقاومة المضادات الحيوية
مقاومة المضادّات الحيويّة هي قدرة الكائن الحيّ الدّقيق على تحمّل مفعول المضادّ الحيويّ. هي نوع خاصّ من أنواع مقاومة الأدوية. تنشأ مقاومة المضادّات الحيويّة طبيعيّا عن طريق الاصطفاء الطبيعي بواسطة التّغيّر الوراثي العشوائيّ، غير أنّه بالإمكان هندستها بتطبيق ضغط نشوئيّ على مجموعة الكائنات الحيّة الدّقيقة. عندما يتمّ تكوّن الجينة الجديدة، تستطيع البكتيريا تحويل المعلومات الوراثيّة بطريقة أفقيّة (ما بين الكائنات الدّقيقة) بواسطة تبادل البلازميد (الحمض النّووي الدّائريّ). إذا كانت البكتيريا تحمل عدّة جينات مقاومة, يتمّ تسميتها بكتيريا متعدّدة المقاومة أو بلغة أخرى البكتيريا المتفوّقة.

الأسباب
مقاومة المضادّات الحيويّة تظهر نتيجة النّشوء عن طريق الاصطفاء الطّبيعي. مفعول المضاد الحيوي يشكّل ضغطا بيئيّا على البكتيريا لكن التّغيّرات الوراثيّة الجينيّة اللّتي تظهر في بعض الخلايا البكتيريّة تجعلها تنجو من مفعول المضاد الحيوي. بعد ذلك، تنتقل هذه الميزة إلى النّسل المقبل الّذي يتميّز بكونه جيلا ذو مقاومة كاملة للمضاد الحيوي. بيّنت عدّة دراسات أنّ طريقة استعمال المضادات الحيوية تؤثّر بصفة كبيرة على تطوّر عدد الكائنات الحيّة الدّقيقة المقاوِمة. فرط استعمال المضادات الحيوية ذات الطيف الواسع، مثل سيفالوسبورين من الجيل الثّاني والثّالت، يسرّع عمليّة تطوّر مقاومة المثيسلين. هناك عوامل أخرى تتمثّل في التّشخيص الطّبّي غير الدّقيق، وصف الطّبيب أدوية غير ضروريّة، الاستعمال غير المناسب للمضادّات الحيويّة من طرف المريض، إلى جانب استعمال المضادّات الحيويّة كموادّ إضافيّة لطعام المواشي لتشجيع نموّها.
أكّد العلماء مؤخّرا أنّ البروتين البكتيري LexA يلعب دورا هامّا في التّغيّر الوراثي البكتيري. [1]
آليّة عمليّة مقاومة المضادّات الحيويّة

مقاومة المضادّات الحيويّة تتمّ عبر أربع طرق:
- تثبيط أو تغيير المضادّ الحيويّ: مثل التّثبيط الإنزيمي للبنسلين ج Penicillin G عند بعض البكتيريا المقاومة للبنسلين عن طريق تصنيع بيتا لكتاميز ß-lactamases
- تغيير موقع الهدف (موقع فعاليّة المضادّ الحيويّ): مثل تغيير ال PBP –موقع فعاليّة البنسلين- عند نوع من البكتيريا يدعى العنقوديات الذهبية المقاومة للمثسلين MRSA، كذلك عند بكتيريا أخرى مقاومة للبنسلين.
- تغيير الطّريق الأيضيّ: بارا أمينو بنزويك أسيد PABA هو عامل مهمّ لصنع حمض الفوليك والأحماض النّوويّة لدى البكتيريا، يمكن تثبيط هذا العامل عن طريق السّلفوناميد. غير أنّ بعض البكتيريا المقاومة للسّلفونميد تستغني عن هذا العامل الأساسيّ عن طريق استعمال حمض الفوليك الجاهز (بأخذه مباشرة من محيطها مثلا)، تماما مثل الخلايا الحيوانيّة.
- التّقليل من تراكم المضادّ الحيويّ: عن طريق التّقليل من نفاذيّة المضادّ الحيويّ إلى داخل الخليّة و/أو تسريع التّدفّق النّشط (الضّخّ إلى المحيط) للأدوية عبر الغشاء الخلويّ البكتيريّ.
الكائنات الحيّة الدّقيقة الممرضة و المقاومة
العنقوديات الذهبية

العنقوديات الذهبية أو بلغة مختصرة ستاف أوريوس أو عدوى السّتاف هي واحدة من أهمّ الكائنات الحيّة الدّقيقة الممرضة و المقاومة. تتواجد هذه البكتيريا على البشرة و الأغشية المخاطيّة لثلث السّكّان تقريبا. هذا النّوع من البكتيريا يتكيّف إلى حدّ كبير مع ضغط المضادّات الحيويّة. تعتبر العنقوديات الذهبية أوّل بكتيريا طوّرت مقاومة ضدّ البنسلين في عام 1948م أعواما قليلة (أربع سنوات) بعد بيع البنسلين بكمّيّات كبيرة. بعد تطوّر المقاومة ضدّ البينيسيلين، تمّ استعمال المثسلين بدلا عن البينيسيلين لكن بسبب ظهور تسمّم الكليتين نتيجة استعمال الميثيسيلين، تمّ استبداله هو الآخر ب الأكساسلين. تمّ اكتشاف العنقوديات الذهبية المقاومة للمثسلين MRSA لأوّل مرّة في بريطانيا عام 1961م. تعتبرالعنقوديات الذهبية المقاومة للميثيسيلين مسؤولة عن 37% من الحالات القاتلة لتسمّم الدّمّ في بريطانيا في عام 1999م بعدما كانت 4% عام 1991م. هذه الظّاهرة منتشرة الآن بحدّة في المستشفيات.
نصف حالات عدوى العنقوديات الذهبية بالولايات المتّحدة الأمريكيّة مقاومة للبنسلين، المثسلين، التتراسايكلن، و الإرثرومايسن.
و بالتّالي فإنّ الفانكومايسن يعتبر المضادّ الحيوي الوحيد ذو فعاليّة في وقتنا المعاصر. لكن تمّ كشف عنقوديات ذهبية مقاومة للفانكومايسين باليابان عام 1996م. عثر عليها كذلك ببعض مستشفيات بريطانيا، الولايات المتّحدة الأمريكيّة و فرنسا. أطلقت أسماء أخرى على العنقوديات الذهبية المقاومة للفانكومايسين مثل ببتيد سكّري-وسيط العنقوديات الذهبية أو العنقوديات الذهبية الغير حسّاسة للفانكومايسين. هذا ما يدلّ على المقاومة لكلّ المضادّات الحيويّة ذات الطّبيعة الببتيدو سكّريّة.
تمّ تطوير صنف جديد من المضادّات الحيويّة، الأكزازولدينون الّذي أصبح جاهزا في التّسعينيّات. وأوّل أكزازولدينون تمّ بيعه يسمّى لنزوليد الّذي يمكن مقارنته مع الفانكومايسين من حيث الفعّاليّة ضدّ العنقوديات الذهبية المقاومة للمثسلين MRSA. للأسف، تمّ تسجيل حالة العنقوديات الذهبية المقاومة للّينيزوليد عام 2003م.
انبثقت العنقوديات الذهبية المقاومة للمثسلين المكتسبة من المجتمع كوباء متسبّب في أمراض مستفحلة و مميتة مثل ذات الرّئة المتنكرزة/النّاخرة، انتان خطير، التهاب اللّفافة النّاخر/المتنكرز. [2]
إنّ وباء العدوى الّتي تعود إلى العنقوديات الذهبية المقاومة للمثسلين يتغيّر بسرعة. يوجد نسيلتين من العنقوديات الذهبية المقاومة للمثسلين بالولايات المتّحدة الأمريكيّة، هذان النّسيلتين هما USA400 (فصيلةMW2، سلالةST1) وUSA300 و تعتبران مسؤولتين عن الأمراض المتفشّية بالمجتمع.النّسيلتين في غالب الأحيان تحتويان على جينات بانتون-فالونتاين لوكوسيدين (PVL) كما تعلّق وجود هذين النّسيلتين بالعدوى المرتبطة بالجلد والأنسجة الرّخوة. تمّ تسجيل حالات أوبئة عدوى العنقوديات الذهبية المقاومة للميثيسيلين المتفشّية بالمجتمع في السجون، عند الفرق الرّياضيّة،القوّات العسكريّة، الأطفال المولودين حديثا بديار الحضانة و اللّواطيّين. [3]
أونتيروكوكوس فاريسيوم
أونتيروكوكوس فاريسيوم هي بكتيريا أخرى متعدّدة المقاومة متواجدة بالمستشفيات. لوحظت الأونتيروكوكوس المقاومة للبنسلين في عام 1983م أمّا الأونتيروكوكوس المقاومة للفانكومايسن فقد لوحظت عام 1987م و الأونتيروكوكوس المقاومة للّنيزوليد في أواخر التّسعينيّات.
العقديّات المقيّحة
يمكن علاج عدوى مجموعة A عقديّات(GAS) بمضادّات حيويّة مختلفة. يمكن للعلاج المبكّر أن يخفّض خطر الموت جرّاء العدوى بمجموعة A للعقديّات الغزويّة. بالنّسبة للأشخاص المصابين بعدوى خطيرة جدّا فإنّ الرّعاية بمراكز العناية المركّزة ضروريّة. أمّا الأشخاص المصابين بالتهاب اللّفافة النّاخر/المتنكرز فإنّهم يحتاجون لعمليّة جراحيّة لإزالة الأنسجة المخرّبة. ظهرت فصائل العقديّات المقيّحة المقاومة للمضادّ الحيويّ ماكرولايد، غير أنّ كلّ فصائل العقديّات المقيّحة تعتبر حسّاسة للبنسلين. [4]
العقديّات الرّئويّة
مقاومة العقديّات الرّئويّة للبنسلين والمضادّات الحيويّة من صنف بيتا لاكتام في ازدياد في العالم. من أهمّ آليّة عمليّة المقاومة الطّفرات الوراثيّة بالجينات النّاسخة للبروتينات المرتبطة بالبنسلين. يلعب الضّغط الانتقائي دورا مهمّا كما يعتبر استعمال المضادّات الحيويّة من صنف بيتا لاكتام عامل خطر للإصابة بالعدوى. تعتبر العقديّات الرّئويّة مسؤولة عن الأمراض التّالية: ذات الرئة، تجرثم الدّمّ، الْتهاب الأذن الوسطى، التهاب السحايا، التهاب الجيوب، الْتهاب الصفاق، التهاب المفاصل. [4]
تمّ اكتشاف العقديّات الرّئويّة المقاومة للبنسلين لأوّل مرّة عام 1967م.
المتقلّبة
يمكن للمتقلّبة أن تسبّب عدوى بالمسالك البوليّة إلى جانب العدوى المكتسبة من المستشفيات. المتقلّبة فريدة من نوعها لأنّها كثيرة الحركة كما أنّها تشكّل مستعمرات غير منتظمة. في الحقيقة، تشكّل المتقلّبة ما هو معروف بالمستعمرات غير المنتظمة و المتسلّقة عندما يتمّ زرعها على وسط غير مثبّط. من أهمّ أعضاء عائلة المتقلّبة المتقلّبة الرّائعة الّتي تسبّب عدوى الجروح و عدوى المسالك البوليّة. معظم فصائل المتقلّبة الرّائعة حسّاسة للأنبسلن و السّيفالوسبورين. لكن المتقلّبة الاعتياديّة ليست حسّاسة لهذه المضادّات الحيويّة كما أنّها توجد بقلّة و تتواجد بكثرة بالأشخاص مكبوتي المناعة. توجد المتقلّبة الاعتياديّة طبيعيّا في أمعاء الإنسان كذلك في أنواع مختلفة من الحيوانات، السّماد العضوي، التّربة و المياه الملوّثة.
أكثر من 80% من عدوى المسالك البوليّة في الإنسان تعود إلى وجود البكتيريا الإشريكيّة القولونيّة لكن عدوى المسالك البوليّة النّاتجة عن المتقلّبة الرّائعة منتشرة أيضا. عندما تلتصق المتقلّبة الرّائعة بجدران المسالك البوليّة فإنّه يوجد احتمال من أن تصيب المتقلّبة الرّائعة الكليتين أكبر من الإشريكيّة القولونيّة. تنتمي المتقلّبة الرّائعة إلى عائلة الأمعانيّات، وهي عبارة عن بكتيريا من نوع السّلبيّة الغرام، متحرّكة و متسلّقة كذلك. تتواجد المتقلّبة الرّائعة ككائنات حيّة دقيقة حرّة بالمياه و التّربة لكنّها تعتبر طفيليّة إذا تواجدت بالمسالك البوليّة العليا لدى الإنسان.
الزّائفة

تعتبر الزّائفة الزّنجاريّة نموذجا مثاليّا للممرضات الانتهازيّة. من الخصائص المقلقة الّتي تتميّز بها الزّائفة الزّنجاريّة قلّة حساسيّتها و تأثّرها بالمضادّات الحيويّة. هذه الخاصّيّة يعود سببها إلى المضخّات المتواجدة على مستوى غشاء الخليّة والّتي تعمل على ضخّ عدّة أدوية، من بينها المضادّات الحيويّة، إلى خارج الخليّة. إلى جانب ذلك، فإنّ الزّائفة الزّنجاريّة تطوّر المقاومة المكتسبة بسهولة، عن طريق الطّفرات الوراثيّة بالجينات الصّبغيّة، أو عن طريق تحويل جينات المقاومة للمضادّات الحيويّة بطريقة أفقيّة من خليّة إلى خليّة.
بعض الدّراسات الحديثة بيّنت أنّ المقاومة النّمطيّة المتعلّقة بتكوّن البيوفيلم أو ببزوغ مستعمرات صغيرة و متفاوتة يمكن أن تكون ضروريّة لاستجابة و مدى تأثّر الزّائفة الزّنجاريّة بالعلاج بالمضادّات الحيويّة. [5]
الكائنات المجهريّة و علاقتها بالحيوانات
العنقوديات الذهبية المقاومة للميثيسيلين معروفة على أنّها كائنات متعايشة و ممرضة مع الإنسان. وجدت العنقوديات الذهبية المقاومة للميثيسيلين في القطط، الكلاب و الأحصنة حيث تتسبّب في نفس أعراض المرض الّتي تظهر بالإنسان. يمكن لعدوى العنقوديات الذهبية المقاومة للميثيسيلين أن تنتقل من الإنسان إلى الحيوان أو العكس، لكنّ الشّائع هو أنّ هذه العدوى انتقلت من الإنسان إلى الحيوان.
حاليا، توجد نسبة معتبرة من المضادّات الحيويّة المدمجة في طعام الحيوانات مثل الدّجاج، الخنازير و المواشي لأغراض غير طبّيّة بالولايات المتّحدة الأمريكيّة. تمّ الرّبط بين استعمال المضادّات الحيويّة في طعام الحيوانات و ظهور فصائل بكتيريّة مقاومة للمضادّات الحيويّة مثل: السّلمونيلة، العطيفة، الإشريكيّة القولونيّة و المكوّرات المعويّة.
هناك دلائل هامّة من الولايات المتّحدة الأمريكيّة و الاتّحاد الأوروبي تؤكّد على أنّ البكتيريا المقاومة تسبّب العدوى المقاومة للمضادّات الحيويّة في الإنسان. دعت كلاّ من الجمعيّة الأمريكيّة للمكروبيولوجيا، الاتّحاد الأمريكي للصّحّة العامّة و الاتّحاد الطّبّي الأمريكي إلى تقييد استعمال المضادّات الحيويّة في طعام الحيوانات مع وضع نهاية لكلّ الاستعمالات غير العلاجيّة.
غير أنّ الشّركات الصّيدلانيّة و شركات صنع طعام الحيوانات احتجّت على هذه القوانين الجديدة الّتي تحدّ من استعمال المضادّات الحيويّة في طعام الحيوانات. مثلا في عام 2000م، أعلنت الإدارة الأمريكيّة للأغذية و الأدوية عزمها على إلغاء التّصديق على استعمال الفلوروكوينولون لدى الدّواجن لأنّه وجدت أدلّة قويّة تربط بين هذا الاستعمال و ظهور عدوى العطيفة المقاومة للفلوروكوينولون لدى الإنسان. القرار الأخير لمنع استعمال الفلوروكوينولون لدى الدّواجن لم يتمّ تطبيقه إلاّ بعد 5 سنوات من إصداره بسبب التّحدّيات من طرف الشّركات الصّيدلانيّة و شركات صنع طعام الحيوانات. [6]
الوقاية من مقاومة المضادات الحيويّة
يمكن لاجتناب استعمال المضادّات الحيويّة، في بعض الحالات، أن يخفّض من فرص الإصابة بالعدوى ببكتيريا مقاومة للمضادّات الحيويّة. أثبتت إحدى الدّراسات أنّ استعمال الفليوروكوينولون مرتبط بشكل واضح بعدوى المطثيّة العسيرة الّتي تعتبر المسبّب الرّئيسي للإسهال المستشفوي بالولايات المتّحدة الأمريكيّة و المسبّب الخطير للموت في العالم. [7]
ليس للّقاحات مشاكل فيما يخصّ المقاومة لأنّ اللّقاح يزيد من المناعة الطّبيعيّة للجسم بينما يعمل المضادّ الحيوي بمعزل عن هذه المناعة. ومع ذلك، فإنّ فصائل بكتيريّة جديدة تتطوّر بحيث تفلت من المناعة النّاتجة عن اللّقاح.
بعض اللّقاحات المضادّة للعنقوديّات أظهرت فعاليّة محدودة بسبب التّغيّر المناعي ما بين سلالات العنقوديّات المختلفة إضافة إلى مدّة الفعاليّة المحدودة للأجسام المضادّة النّاتجة. تطوير و اختبار لقاحات أكثر فعاليّة في طور الإنجاز.
العلاج بالعاثية

تمّت عدّة أبحاث لدراسة هذه الطّريقة العلاجيّة بشكل شامل و تمّ استعمالها لمدّة تزيد عن 60 عاما خاصّة بالاتّحاد السّوفيتي. العلاج بالعاثية يمكن استعماله بدل المضادات الحيويّة وبالتّالي التّقليل من مشاكل المقاومة.
استعمل العلاج بالعاثية بشكل واسع في بالولايات المتّحدة الأمريكيّة إلى حين اكتشاف المضادّات الحيويّة في أوائل الأربعينيّات.
العاثيات عبارة عن فيروسات تغزو الخلايا البكتيريّة، وفي حالة العاثيات المحدثة لانحلال الخلايا، فإنّ العمليّة الأيضيّة لدى البكتيريا تتعطّل فيما يتسبّب في انحلال البكتيريا. [8][9][10]
يعتبر العلاج بالعاثية طريقة بديلة مهمّة عن المضادات الحيويّة في عصر كثرت فيه الكائنات المجهريّة المتعدّدة المقاومة. مراجعة بعض الدّراسات الّتي تناولت الاستعمال الطّبّي للعلاج بالعاثية من عام 1966م إلى 1996م و بعض أحدث المشاريع حول العلاج بالعاثية أظهرت أنّ العاثيات استعملت عن طريق الفم، الطّريق الموضعيّ إضافة إلى الاستعمال الشّامل ( غير الموضعيّ) في دراسات بولنديّة و سوفياتيّة. قدّرت نسبة النّجاح في هذه الدّراسات ب 80% إلى 95% مع وجود بعض الأعراض الجانبيّة مثل المعدمعويّة و الحساسيّة.
بيّنت الأبحاث البريطانيّة فعاليّة معتبرة للعاثيات ضدّ الإشريكيّة القولونيّة، فصائل الرّاكدة، فصائل الزّائفة و العنقوديات الذهبية. أمّا الأبحاث الأمريكيّة فقد ركّزت على تحسين التَوافر البيولوجيّ للعاثيات. [11] [12]
تطبيقات مفيدة لمقاومة المضادّات الحيويّة

تستعمل مقاومة المضادات الحيويّة كأداة مفيدة في مجال الهندسة الوراثيّة. مثلا يتمّ صنع بلازميد يحتوي على مورّثة مقاومة المضادّات الحيويّة إضافة إلى المورّثات المرغوب في ترجمتها، بهذه الطّريقة يتمكّن الباحث من التّأكد ّ من أنّ عند تكاثر الخلايا البكتيريّة فإنّ فقط البكتيريا الحاملة للبلازميد يمكنها العيش أمّا الأخرى فتموت بسبب تأثير المضادّ الحيويّ. و هكذا يمكن لهذه الطّريقة أن تؤكّد أنّ الجينات المرغوب في ترجمتها تنتقل عبر الخلايا عند تكاثرها. في الغالب،المضادّات الحيويّة المستعملة في مجال الهندسة الوراثيّة قديمة كما أنّها لم تعد تستعمل لمعالجة المرضى مثل: الأنبيسيلين، كانامايسن، تتراسايكلن، كلوروفنيكول. يعتبر استعمال طريقة مقاومة المضادّات الحيويّة طريقة غير مفضّلة في المجال الصّناعيّ إذ أنّها تستهلك كمّيّات هائلة من المضادّات الحيويّة. بدلا عن ذلك، يمكن استعمال الفصائل البكتيريّة الأكسوتروفيّة ( غير قادرة على صنع مركّب عضوي مهمّ لنموّها).
المصادر
- ^ Cirz RT, Chin JK, Andes DR, de Crécy-Lagard V, Craig WA, Romesberg FE (2005). "Inhibition of mutation and combating the evolution of antibiotic resistance". PLoS Biol. 3 (6): e176. doi:10.1371/journal.pbio.0030176. PMID 15869329.
{{cite journal}}: CS1 maint: multiple names: authors list (link) CS1 maint: unflagged free DOI (link) - ^ Boyle-Vavra S, Daum RS (2007). "Community-acquired methicillin-resistant Staphylococcus aureus: the role of Panton-Valentine leukocidin". Lab. Invest. 87 (1): 3–9. doi:10.1038/labinvest.3700501. PMID 17146447.
- ^ Maree CL, Daum RS, Boyle-Vavra S, Matayoshi K, Miller LG (2007). "Community-associated methicillin-resistant Staphylococcus aureus isolates causing healthcare-associated infections". Emerging Infect. Dis. 13 (2): 236–42. PMID 17479885.
{{cite journal}}: CS1 maint: multiple names: authors list (link) - ^ أ ب Albrich WC, Monnet DL, Harbarth S (2004). "Antibiotic selection pressure and resistance in Streptococcus pneumoniae and Streptococcus pyogenes". Emerging Infect. Dis. 10 (3): 514–7. PMID 15109426.
{{cite journal}}: CS1 maint: multiple names: authors list (link) - ^ Cornelis P (editor). (2008). Pseudomonas: Genomics and Molecular Biology (1st ed. ed.). Caister Academic Press. ISBN [[Special:BookSources/978-1-904455-19-6 ]|978-1-904455-19-6 ]]].
{{cite book}}:|author=has generic name (help);|edition=has extra text (help); Check|isbn=value: invalid character (help) - ^ Nelson JM, Chiller TM, Powers JH, Angulo FJ (2007). "Fluoroquinolone-resistant Campylobacter species and the withdrawal of fluoroquinolones from use in poultry: A public health success story". Clin Infect Dis. 44: 977–80.
{{cite journal}}: CS1 maint: multiple names: authors list (link) - ^ Frost F, Craun GF, Calderon RL (1998). "Increasing hospitalization and death possibly due to Clostridium difficile diarrheal disease". Emerging Infect. Dis. 4 (4): 619–25. PMID 9866738.
{{cite journal}}: CS1 maint: multiple names: authors list (link) - ^ N Chanishvili, T Chanishvili, M. Tediashvili, P.A. Barrow (2001). "Phages and their application against drug-resistant bacteria". J. Chem. Technol. Biotechnol.). 76: 689–699.
{{cite journal}}: CS1 maint: multiple names: authors list (link) - ^ D. Jikia, N. Chkhaidze, E. Imedashvili, I. Mgaloblishvili, G. Tsitlanadze (2005). "The use of a novel biodegradable preparation capable of the sustained release of bacteriophages and ciprofloxacin, in the complex treatment of multidrug-resistant Staphylococcus aureus-infected local radiation injuries caused by exposure to Sr90". Clinical & Experimental Dermatology. 30: 23.
{{cite journal}}: CS1 maint: multiple names: authors list (link) - ^ Weber-Dabrowska B, Mulczyk M, Gorski A. (2003). "Bacteriophages as an efficient therapy for antibiotic-resistant septicemia in man". Transplant Proc.
{{cite journal}}: CS1 maint: multiple names: authors list (link) - ^ Mathur MD, Vidhani S, Mehndiratta PL. (2003). "Bacteriophage therapy: an alternative to conventional antibiotics". J Assoc Physicians India. 51: 593–6.
{{cite journal}}: Text "PMID 15266928" ignored (help)CS1 maint: multiple names: authors list (link) - ^ Mc Grath S and van Sinderen D (editors). (2007). Bacteriophage: Genetics and Molecular Biology (1st ed. ed.). Caister Academic Press. ISBN 978-1-904455-14-1 .
{{cite book}}:|author=has generic name (help);|edition=has extra text (help)
انظر أيضا
وصلات خارجية
- CDC Article on Hospital Acquired MRSA
- CDC Article on Community Acquired MRSA
- CDC Guideline "Management of Multidrug-Resistant Organisms in Healthcare Settings, 2006"
- ReAct Action on Antibiotic Resistance
- Vancomycin Resistant Enterococcus—Guidelines for Healthcare Workers
- Alliance for the Prudent Use of Antibiotics
- Cox LA, Popken DA (2006). "Quantifying potential human health impacts of animal antibiotic use: enrofloxacin and macrolides in chickens". Risk Anal. 26 (1): 135–46. doi:10.1111/j.1539-6924.2006.00723.x. PMID 16492187.
{{cite journal}}: Unknown parameter|month=ignored (help) - Prudent Use of Antibiotics
- Information about phage therapy – a possible alternative to antibiotics in case of resistant infections
- Antibiotic-resistance genes as markers Once necessary, now undesirable
- CBS Article on Phage Therapy and Antibiotic Resistance
- Hospitals: Breeding the Superbug? Article on MRSA infections in hospitals, Allianz Knowledge, May 2008
- BURDEN of Resistance and Disease in European Nations - An EU-Project to estimate the financial burden of antibiotic resistance in European Hospitals
- Extending the Cure: Policy Research to Extend Antibiotic Effectiveness
- 2003 New Guidance for Industry on Antimicrobial Drugs for Food Animals Questions and Answers, U.S. FDA
- SciDev.net Antibiotic Resistance spotlight The Science and Development Network is an online science and development network focused on news and information important to the developing world
- Do Bugs Need Drugs?